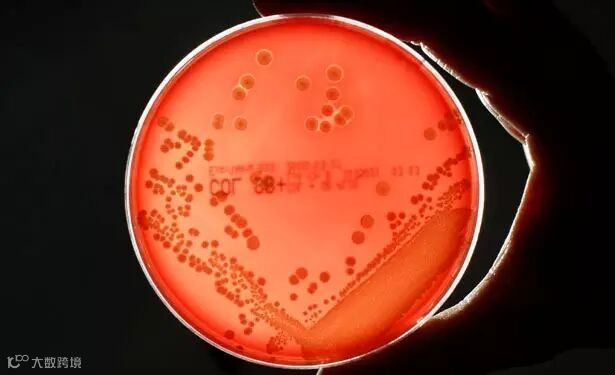

穿过大街小巷,你有没有发现不孕不育医院遍地开花?看尽人来人往,你有没有发现,胖子越来越多?各种稀奇古怪的疾病也常有耳闻?在兽药界,那些闻所未闻的兽药,阉割药?催奶针?含铜铁锌的禁用催肥药?各种抗生素?......更为可怕的是,使用了这些兽药的动物肉、蛋、鱼、奶等,一旦被端上我们的餐桌,导致不孕不育、抗生素使用过量等危害必然势不可挡地呈现于众!

广州市妇婴医院曾抢救过
一名体重仅650克、25个孕周的早产儿。
头孢一代,无效!
头孢二代,无效!!
头孢三代四代,仍然无效!!!
再上“顶级抗生素”
泰能、马斯平、复兴达……通通无效!!!!!!!
后来的细菌药敏检测显示,
这个新生儿对7种抗生素均有耐药性!

话说!
这位妈妈怀孕的时候
到底是吃了多少
“有营养”的抗生素肉?!

上海复旦大学公共卫生学院公布一份有关“江浙沪儿童普遍暴露于多种抗生素”的研究报告,引起广泛关注。这项研究历经1年,对江浙沪1000多名8到11岁在校儿童的尿液监测证实,该地儿童普遍暴露于多种抗生素,背负沉重的抗生素负担。

化验结果让人太!震!!惊!!!
有的甚至被检出6种抗生素
更多内容请看☟下方视频
化验结果表明,这1000多个样本儿童中,至少有58%的儿童尿中检出一种抗生素,1/4的儿童尿中检出2种以上抗生素,有的尿液样本中甚至能检出6种抗生素!

早已不推荐儿童使用的抗生素出现在儿童体内令人担忧,并且,这些抗生素成分在我们生活环境和食品中被经常发现。
儿童体内被检出只限用于
畜禽的抗生素:
金霉素、恩诺沙星、泰乐菌素

不少媒体又不约而同
报道了养殖业中
大量使用抗生素的消息
调查数据触目惊心

日本东京发现“超级细菌”
已致5人死亡、5人病危
目前尚无药物可治

宁夏、济南等地
也出现了“耐药宝宝”
这都是孕妇吃大量含有
抗生素残留的肉蛋禽等食品造成的

为了防止大量圈养的
集中养殖的畜禽不生病
畜禽养殖会大量使用抗生素

孩子食用了含有抗生素的
家禽、家畜的肉、奶等
就可能会累积这些抗生素成分


记者还暗访发现,抗生素乱排滥用并不罕见,南京自来水甚至检出阿莫西林…全国主要河流黄埔江、长江入海口、珠江都检出抗生素!

农业污染也是抗生素来源之一。比如使用抗生素养鱼、地下水排放等途径,都会污染河流。并且,抗生素被机体排出后,通过土壤、水体等环境介质产生污染,这些环境中残留的抗生素又会通过生物链对人体构成潜在危害。

动物一半人吃一半
中国是抗生素使用大国,也是抗生素生产大国:年产抗生素原料大约21万吨,出口3万吨给世界人民,其余18万吨留给自己用(包括医疗与农业使用),近半抗生素用于动物养殖。

目前,抗生素滥用问题已经成为我国一个重大的公共卫生问题;中国的抗生素滥用已引来世界卫生组织数次警告。

■ 中国每年生产抗生素原料大约21万吨,其中46.1%被用在了畜牧养殖业。
— — 北京大学临床药理研究所肖永红教授
■ 有关监管部门应该像重视监管"瘦肉精"生猪一样,重视监管"抗生猪""抗生
鸡"和"抗生鱼"。
— — 广东省农业厅动物营养专家林树斌

从上世纪50年代开始,美国很多农场主发现,经常给牛、猪或者鸡喂低于治疗剂量的抗生素,不仅可以降低饲料喂养量,还能实现加速它们增加体重的神奇效果,可谓一举两得。因此这种做法很快得以推广开来,蔓延至全球。
一张图看懂抗生素的利与弊


卫生组织曾多次表示,如果抗生素的滥用造成细菌的耐药性,当人类面临传染病的时候,可能出现无药可用的危险状况。

世界卫生组织今年最新发布的《抗菌素耐药:全球监测报告》,列举了人类对7种不同抗菌素耐药性的事实,而与之相关的7种细菌则是导致几种常见严重疾病的原因,例如血液感染(败血症)、腹泻、肺炎、尿路感染及淋病。
报告指出,抗生素耐药性已成全球危机,而抗生素危机将比上世纪80年代的艾滋病疫情更加严重。

卫生部人士曾表示,目前我国每研制一种抗生素要10年,而细菌产生耐药性只需两年。“如果我们再不加以控制,过不了多长时间老百姓看病吃药就没有有效的抗生素可以用了。”

美国《研究显示全球抗生素使用增长令人震惊》的报道称,全球抗生素使用10年里增长36%,其中大部分情况是滥用。报告作者对71个国家从2000年到2010年的抗生素使用情况进行了长期和全面的跟踪。调查发现,这种增长似乎与经济发展同步。而抗生素消费的增长,有3/4来自几个经济正在快速增长的国家,包括巴西、俄罗斯、印度、中国和南非。

养殖业一线工人受到的抗生素伤害(1)
两年前,里夫斯在美国阿肯色州贝茨维尔市一个家禽肉类加工厂工作。一天,他突然发现右眼有个肿块。
“这个肿块,开始只有蚊子咬的包那样大,后来变得跟西柚一样大。” 医生诊断,里夫斯感染了耐甲氧西林金黄色葡萄球菌(MRSA,对青霉素耐药,下文简称“耐药葡萄状球菌”)。医生尝试用通常管用的抗生素,来治疗这种差点让里夫斯丧命的感染。
里夫斯惊悚地回忆说:“你本来在正常上班,正常过日子,却被医生突然告知可能在数小时内死去。”

美国每年2.3万人因”抗生素肉”死亡
美国联邦食品和药品局(FDA)决定从2014年开始,用3年时间禁止在牲畜饲料中使用预防性抗生素。
FDA此番之所以痛下决心,原因在于美国畜牧业对抗生素的滥用已经到了触目惊心的地步:美国高达80%的抗生素被使用在畜牧业养殖上。
长期摄入“抗生素肉”令人体产生抗药性,每年大约有2.3万美国人因此而死亡。
养殖业一线工人受到的抗生素伤害(2)
乔伊斯,在美国皮尔格林•普赖德公司经营的小鸡孵化场工作。她感染耐药葡萄状球菌已经超过10次,治疗时必须不断轮换药物。
“真的非常痛苦。打针没用,因为我被感染得太厉害了,打针没多大帮助。”乔伊斯说,短短数周之内,她所在的小鸡孵化场,有37人都感染了这种耐药菌。这些感染者,最后起诉了皮尔格林•普赖德公司。

一直以来,欧盟有着严格的食品安全标准,对转基因食品、瘦肉精、抗生素、农药残留等方面的监管和控制非常严格。此外,由于欧洲近年来爆发了数次食品安全危机,欧洲消费者纷纷要求食品生产商提高信息透明度。

上世纪70年代,欧盟就开始暂停批准将几种主要的抗生素加入动物饲料中。
1986年,瑞典全面禁止在畜禽饲料中使用抗生素,成为第一个不准使用抗生素作为饲料添加剂的国家。
从2006年1月起,欧盟禁止黄霉素、效美索、盐霉素和莫能霉素等最后四种抗生素作为促生长饲料添加剂使用。如今,欧盟已经基本实现动物饲料中不添加抗生素。

全球每年数百亿只鸡与几十亿头牲畜被作为肉食饲养,不但产生耐药性,而且会引起超级细菌和变异的病毒,发生人类无法预先防御的大规模的疫情,比如SARS,H7N9。这只是个概率问题。

上海膳首健康管理有限公司董事长翁金祥先生十分痛心于抗生素污染的现状,他希望人们能吃上无抗生素、无添加剂、无重金属的食物,于是,经过多年调研,终于发现了一种可以解决这个问题的植物——菌草。通过种植能在恶劣条件下生长的菌草,制成有机饲料,养殖猪、羊、鸡鸭等,从源头杜绝了抗生素污染,并且动物粪便经过处理后,可以用来种植有机蔬果,可谓一举多得。该菌草生态有机产业链目前已在运行当中,生态猪肉和富硒灵芝蛋投入市场后反响热烈,很多人品尝过的客户纷纷赞其味道纯粹。健康事业是膳元集团矢志不渝的目标,为了让子孙后代不再遭受抗生素、激素等的毒害,从现在起,一定要吃得健康!膳元与你风雨同舟!

守护孩子最好的方式
就是给他吃最健康的食物
陪他一起快乐成长!


点击“阅读原文”了解更多细胞养护知识


